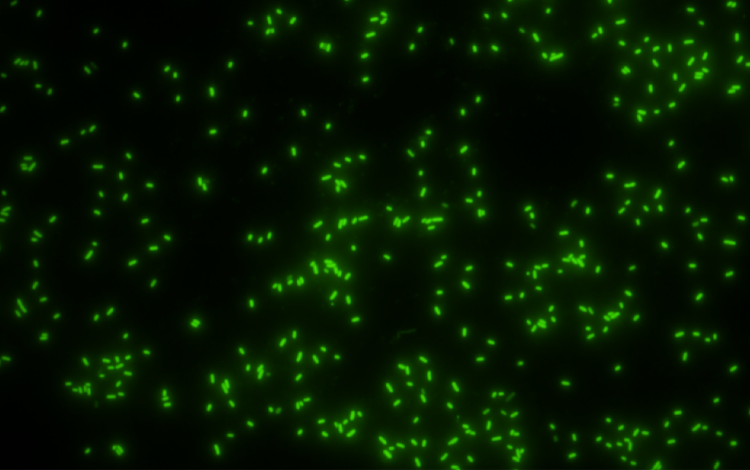
【仅余3席】在苏州参加牛津官方夏校,助力学员化身专业生物化学科研人员 【仅余3席】在苏州参加牛津官方夏校,助力学员化身专业生物化学科研人员

克隆羊多利,科幻电影中的奇幻场景……这些都曾让我们对克隆技术充满想象。 但其实,分子克隆技术早已走出实验室,广泛应用于临床诊断和基因工程等领域,例如: 复制遗传性疾病或癌症患者的DNA进行分析,或用于转基因动植物的研发。 然而,生物化学领域的突破远不止于此...

许多代谢紊乱疾病,例如白化病(因缺乏酪氨酸羟化酶而引起),都与酶的改变密切相关。2018年诺贝尔化学奖授予弗朗西斯·阿诺德,表彰其在“酶的定向进化”领域的杰出贡献,这一成就被誉为“人类控制了进化”。通过模拟和加速自然进化过程,科学家们能够定向改造酶的特性,使其拥有更高的催化效率或更强的选择性,从而用于制造生物燃料、药物等各种物质。从克隆技术到酶的定向进化,生物化学的进步正不断改变着我们的世界!
每年寒暑假,都有一批对生物、化学、分析生物学感兴趣的的高中生,在苏州参加牛津STEM实验研究型官方夏校及冬校。同学们将前往牛津高等研究院(苏州),在牛津大学教授/科学家/研究员的带领下,开启了生物化学方向:《利用分子克隆技术用荧光蛋白将细菌进行标记》和《蛋白质的人工突变进化实现对酶催化反应活性与选择性的操控》两个课题的十日集训,项目由理论lecture+实验实践+科研workshop组成,一起来看看往期精彩回顾吧:

在《生物化学:利用分子克隆技术用荧光蛋白将细菌进行标记 蛋白质的人工突变进化实现对酶催化反应活性与选择性的操控》的课题中,两组的同学们将在10天的学习周期里,重点进行对分子生物学的发展历史、以及基本实验技术原理和应用进行深入学习。
其中分子克隆组的同学,会在实验室侧重于进行重组蛋白表达实验。想象一下,科学家想要一种特定的蛋白质,但从自然来源提取它太困难或成本太高,此时,重组蛋白表达实验就派上用场了。重组蛋白表达技术广泛应用于生物医药、工业酶制剂等领域,例如生产治疗性蛋白质药物、诊断试剂等。它让我们能够大规模、高效地生产各种蛋白质,为科学研究和工业生产提供了强有力的工具。
蛋白质酶催化组的同学,会进行酶的人工突变原理以及催化反应结果的分析实验。 酶是生物体内重要的催化剂,它们能显著加快化学反应的速度。酶的人工突变是一种强大的工具,可以用来研究酶的结构和功能,并设计出具有改进特性的新型酶。 通过对酶进行定向进化或理性设计,科学家们可以获得催化效率更高、选择性更好、甚至具有全新功能的酶,应用于生物燃料生产、药物研发等众多领域。
除了实验以外,生物化学课题组也会穿插非常重要的理论知识讲解,如:DNA和RNA的结构与功能、PCR技术以及DNA甲基化等核心内容。
这种“理论-实验”的双轨模式,引导同学们在认知与实践中逐渐构建清晰的知识体系。
夏校瞬间
牛津苏州
●理论课堂:了解实验仪器的作用
项目第一天,同学们认真学习了生化实验仪器的作用以及使用方法,比如:如何使用移液枪、锥形瓶的作用、不同尺寸的培养皿。同学们参观了分子生物学实验室的其他仪器设备,例如:用于核酸固定和杂交的真空加热干燥箱,用于凝胶干燥的电泳凝胶干燥箱,以及各种离心机、超纯水机、冰箱等辅助设备。 这些仪器设备共同构成了一个功能完善的分子生物学实验室。同学们了解了超多实验室干货,为接下来高强度的实验实操打下基础!
往期瞬间
牛津苏州

●理论课堂:了解核磁共振波谱法
核磁共振波谱仪 (Nuclear Magnetic Resonance Spectroscopy, NMR) 是一种强大的分析技术,用于研究原子核对射频辐射的吸收。通过分析原子核在强磁场中的行为,NMR 可以提供关于分子结构、动态过程和化学反应的丰富信息。同学们学习这一技术将大范围的运用在之后实验中:研究生物大分子(如蛋白质、核酸等)的结构和动态变化,了解生物分子的功能和作用机制。
往期瞬间
牛津苏州

●理论课堂:了解PCR、凝胶电泳等
实验室操作台的玻璃罩上,是同学们临时使用的“黑板”,老师在上面写满了化学分子式,同学们也在认真的听讲,做笔记。导师们介绍了基础的生物实验技术,比如:PCR(聚合酶链式反应),凝胶电泳,以及转化技术。

在正式进入实验室前,除了理论知识外,每位同学都需要认真学习实验室安全须知与操作规范(虽然阅读风险评估与SOP文件会有一些枯燥,但这是必不可少的环节哦)。
在生物化学课题组,同学们会进行高强度的大量实验。第二天大家就换上了实验服,正式走进实验室里开始动手实验了,来看一下同学们都进行了哪些实验吧:
🧪利用分子克隆技术用荧光蛋白将细菌进行标记
荧光蛋白组的同学进行了绿色荧光蛋白(GFP)基因克隆及构建载体的实验。在这个实验里,同学们要从含有GFP基因的模板中克隆出该基因,并将其构建到合适的载体上,以便后续进行表达和研究。具体操作如下:
首先,同学们需准备含有GFP基因的质粒或基因组DNA作为模板DNA。接着,依据GFP基因序列和载体多克隆位点,设计两端引入合适酶切位点的引物。同时,要选择合适的表达载体。此外,同学们还在导师的指导下准备引物酶切位点对应的限制性内切酶、T4 DNA连接酶以及连接缓冲液。
下一步,需要进行GFP基因的PCR扩增,同学们要在无菌PCR管中按照配方精确加入各种成分,这一步骤对学生们精细操作实验的能力是个不小的考验。完成PCR扩增后,同学们还需要对PCR产物和载体分别进行酶切,即分别配制相应的酶切体系。
“我通过生物手段进行了有机合成。我学会了如何通过PCR引入DNA变异,并且将DNA引入细菌体内进行蛋白质表达。同时,我也在这次活动中做了我自从开始学化学以来第一个有机实验。这次项目使我对生化的前沿研究有了进一步的了解。我之前一直认为有机化学就有氧化还原、Addition、substitution、Elimination、cyclization这几类反应,我之前的思路也仅限于这些,但是我发现有机化学的前沿竟然是大分子生物学 ”
———胡同学
🧫蛋白质的人工突变进化实现对酶催化反应活性
与选择性的操控
蛋白质人工突变组的同学们需要通过对细胞色素P450基因进行诱变,获得具有新功能或特性的突变体,为后续研究其功能和应用奠定基础。首先同学们需要准备含有细胞色素P450基因的质粒或基因组DNA、其次同学们需要根据诱变位点设计带有突变碱基的引物以及PCR反应体系相关试剂。
除了进行上述的实验以外,同学们也掌握到了所做实验相关的,现代生物学研究中应用非常广泛的基础实验技术,分别是Dpn I酶切及转化,和吉布森组装法构建质粒。
Dpn I酶切及转化能利用Dpn I酶专门切割甲基化DNA的特点,在PCR扩增后把模板DNA去掉,方便后续实验。吉布森组装法构建质粒则是靠几种酶的组合,能高效地把好几个DNA片段连起来,在构建质粒时特别有用。
”来之前完全没有想到可以这么有趣,组内的氛围很轻松欢乐。大家一起探索未知领域知识的过程很艰难但又很开心,之前从未接触过的不管是PCR还是mini-prep等,很多对我来讲很新鲜的实验都让我对项目增加了一丝兴趣,也让我对“酶”和DNA有了更深的见解 ”
———周同学
如果同学们以后想读分子生物学专业,那在高中阶段学会这两种实验方法很有必要。这能让同学们早点熟悉分子生物学实验的操作,锻炼动手能力和科学思维,给以后深入学习分子生物学打个好底子。



在为期 10 天紧凑而充实的课程中,两个小组的同学一边深入学习生物化学知识,一边通过密集的实验训练掌握了多项科研技能,真切体验了“科研人员”的日常工作。
对于生物化学小组来说,实验环节至关重要。他们需要精心规划每一个实验步骤,并且以十足的耐心等待实验结果。然而,实验过程并非总是风平浪静,当出现与预期不符的偏差时,同学们需要积极主动地分析原因,及时调整实验方案。这样的经历,不仅提升了他们的科研能力,也锤炼了他们的心理素质。
荧光蛋白小组在通过“凝胶电泳”检测扩增结果后,同学们使用吉布森组装法将 GFP 基因与载体拼接。同学们将 PCR 扩增的 GFP 基因片段、线性化载体和组装混合液放入无菌离心管,在 50℃下反应 1 小时,然后将反应产物转移到“大肠杆菌感受态细胞”中进行转化。
转化成功后,同学们挑选单菌落放入含抗生素的 LB 培养基中培养。培养后提取质粒,进行 DNA 测序和琼脂糖凝胶分析,以确认 GFP 基因是否正确克隆到载体上。
确认无误后,同学们挑选含 GFP 质粒的单菌落继续培养。当菌液的 OD₆₀₀值达到 0.6 - 0.8 时,同学们加入诱导剂,在 20 - 30℃下振荡培养以促进 GFP 表达。
最后,同学们在导师的指导和帮助下取一滴菌液滴在载玻片上,盖上盖玻片,放在显微镜下,打开荧光光源并选择滤光片,观察到如下图所示的: GFP 发出的绿色荧光。
蛋白质人工突变小组在进行了凝胶电泳以及转化等基础实验操作之后,又开展了P450 基因诱变实验,进行 Dpn I 消化并将消化产物转化入大肠杆菌感受态细胞。
接着他们制备并高压灭菌 LB 培养基,接种转化体进行小量提取,将部分培养物转接至烧瓶为酶制备做准备。随后进行质粒提取,送测序公司测序并通过琼脂糖凝胶分析质粒,同时诱导表达 P450 酶并对测序结果进行数据分析。
最后同学们收获细胞并进行酶纯化,设置酶促反应,进行反应萃取和样品制备,通过气相色谱分析并进行数据分析,以计算酶促反应的转化率、选择性等参数。
在此期间,部分同学的实验结果可能不尽人意。(如下图显示了DNA片段长度分析:样品1、2和6的长度为5000 bp。样品3和6的长度分别为750 bp和1500 bp。样品4和5未能得到结果)

但这并不意味着他们的努力没有价值,实验本身就是一个探索和学习的过程,失败往往是成功的前奏。项目中,同学们会面对不同的实验结果,如果第一次的结果不太理想,大家可以从中总结经验,分析问题所在,反思和寻找改进的方法。下一次就会离成功更进一步。



对于每一次的实验的结果,同学们对此印象非常深刻:
黄同学说到:“我们第一次培养大肠杆菌的时候一个都没有养活,我觉得这是一个非常有趣的错误。老师们都很有耐心,会一点一点教我们做每一步的实验,虽然有时候可能会遇到一些问题。”
王同学:我学到了很多关于基因工程和蛋白表达的知识。在这10天里,我获得了宝贵的实验经验,体验了作为research scientists 的生活。虽然我们第一次的实验结果不尽人意,但是经过了反思和改良,我们第二次的实验结果就比较成功。


结业汇报中,生化小组的同学们不仅要完成演讲PPT、也要完成课题相关Essay的写作,所以同学们也在导师的指导下学习了结业论文的的结构,写作方法等知识。 虽然课业量比较多,但是同学们都觉得收获满满。
部分结业汇报课题展示:
Selective hydroxylation of Valencene to Nootkatone using a strain of P450 with mutations at R47, Y51, S72, F87, H171, Q307, N219, A328, A330.
Catalytic Efficacy of the A330V Mutation in Cytochrome P450BM3 (CYP102A1) for the Synthesis of Nootkatone .

应对生活中的复杂问题时,通常无法用一个单一的学科来解决,跨学科思维可以帮助同学们打破学科壁垒,获取更多的学术灵感。
所以在理论lecture、实验室实践之外,夏校期间还会有一系列由牛津大学教授、研究员精心策划的科研分享工作坊,如《聚焦DNA和RNA、PCR及DNA甲基化关键知识》、《跨学科科研之路》、《如何成为一名科学家:科研素养培养》...
10天的日程转瞬即逝,同学们在不舍中结束了这段难忘的夏校之旅,也留下许多珍贵的留言。愿同学们在未来,都能绽放属于自己的学术光芒。
学生留言:
第一次进这种非常正式的Lab,本来以为会很严肃,结果发现老师们人都超级好,非常包容,也会耐心的带着我们一步一步来,完全消除了对于实验的那种恐惧和未知感,当然越发坚定了以后要在实验室搬砖的决心。生化组的研究员老师们人都特别好,完全没有架子,像是学长老师一样,把细节和知识点细细的讲给我们。
在Oscar的这10天的更像是一场圆梦之旅:对于几乎没有进过实验室的我来说,生物学一直是课本知识中那些精妙的理论和原理,是前人智慧的累积,又似高岭之花一般吝啬于将其全貌展现于我们面前,继而便有了敬畏——不仅是对实验室,在和导师研究员的交流中,我既看到了生物学实验中商品化的成熟和操作的简便,远不是那么晦涩抽象,我也认识到了自己在科研这条路上的道阻且长。
我既看到了差距,却也发现这远不是我以为的吐鲁番到珠穆朗玛峰的距离;我也找到了信念,仿佛沿着你们走过的路,描摹着你们曾留下的脚印,也可以挪到理想的终点。老师们,非常感谢你们在我实验之路伊始留下的烛火,从此前路漫漫,却也可聊以慰藉,惶恐不复。
——西北工业大学附属中学,张同学


2025寒假,录取学员合影,来自:宏文学校青岛校区、 南京师范大学附属中学IB部 、苏州市相城区诺德学校 、成都市郫都区天立学校 、上海光华启迪 、北京市朝阳区人朝分实验学校 、北京哈罗英国学校 、黑龙江省实验中学 、新加坡國際學校(香港) 、领科教育上海校区 、西北工业大学附属中学 、北京市二十一世纪学校
- 项目介绍-

牛津大学高等研究院(苏州)是英国牛津大学在中国设立的首个及目前唯一的自然科学和工程研究中心,主要对牛津大学数学、物理和生命科学学部的科研工作进行拓展。研究院以牛津大学雄厚的科研实力为立身之本,引领现代生物技术、先进材料、计算方法和制造技术的研究,为当前全球医疗、能源、环境和金融挑战提供创新解决方案。
2023 年,牛津大学高等研究院(苏州)与阿思丹(ASEEDER)达成战略合作,联合组织牛津大学高等研究院(苏州)冬校/夏校,收获了众多学子的一致好评!
2026年暑假,牛津STEM实验研究型夏校(苏州)重磅回归,致力于带领优秀高中生亲临世界一流的科研环境,近距离了解具有全球影响力的颠覆性技术和尖端科研成果,并通过深度学习与实践,提升跨专业、跨文化的科研素养,挖掘科研学术潜力,打开全球化科研视野。
- 2026暑假课题 -
| 学科领域 | 可选课题 | 名额 |
| 物理光电研究 | 第三代薄膜太阳能电池 | 8-10 |
| 诺奖之光 : 基于量子点的新型光源 | 8-10 | |
| 智能变色的奥秘:电致变色技术 | 8-10 | |
| 医学工程 | 再生医学技术与组织工程的未来前沿 | 8-12 |
| 生物技术 | 前沿生物技术以应对健康与环境挑战 : 从人工智能设计到生物验证 | 8-12 |
| 低碳能源 | 用于生产绿色氢气的膜电极工艺开发 | 8-12 |
| 温控储能 | 看不见的能量调控 -- 相变储能材料与未来热管理技术 | 6-10 |
| 生物化学 | 利用分子克隆技术用荧光蛋白将细菌进行标记 | 5-6 |
| 蛋白质的人工突变进行实现对酶催化反应活性与选择性的操控 | 5-6 |
项目时间:7月20日-7月29日(10天集训)
学习地点:牛津大学高等研究院(苏州)
适合对象:建议项目开始前已满16周岁
授课语言:英文辅以中文(* 实验室操作过程以及部分难度较高的理论知识将进行中英文教学,帮助学生理解。)
* 每位学生仅可选择一个课题
- 选拔标准-
符合以下任意一条的同学,可直接录取:
• 在阿思丹 EPQ 研究性学习认证获得申请学科相关课题成绩 B 及以上
• 雅思 6.0 分或托福 80 分语言成绩,学科 A 及以上成绩或(I)GCSE 对应学科 7 分及以上
• 如果没有达到以上标准,需接受阿思丹(ASEEDER)老师的英文面试(电话或在线)
- 申请流程 -
01
递交申请
02
缴纳费用并签署协议
成绩单审核/面试通过后,缴纳项目费用、签署项目协议,等待项目开始。
03
与课题组在线会面(6-7月)
被录取的学生将在6-7月以小组在线会面的形式,接受课题组导师考察,从而了解学生英文及学科水平。
04
项目开始前一天抵达苏州
建议非苏州本市学生购买项目开始前一天的航班或动车,以便准时参加项目。
05
参与项目,收获学术产出与证书
项目结束后,顺利完成项目全程的学生将获得项目证书
